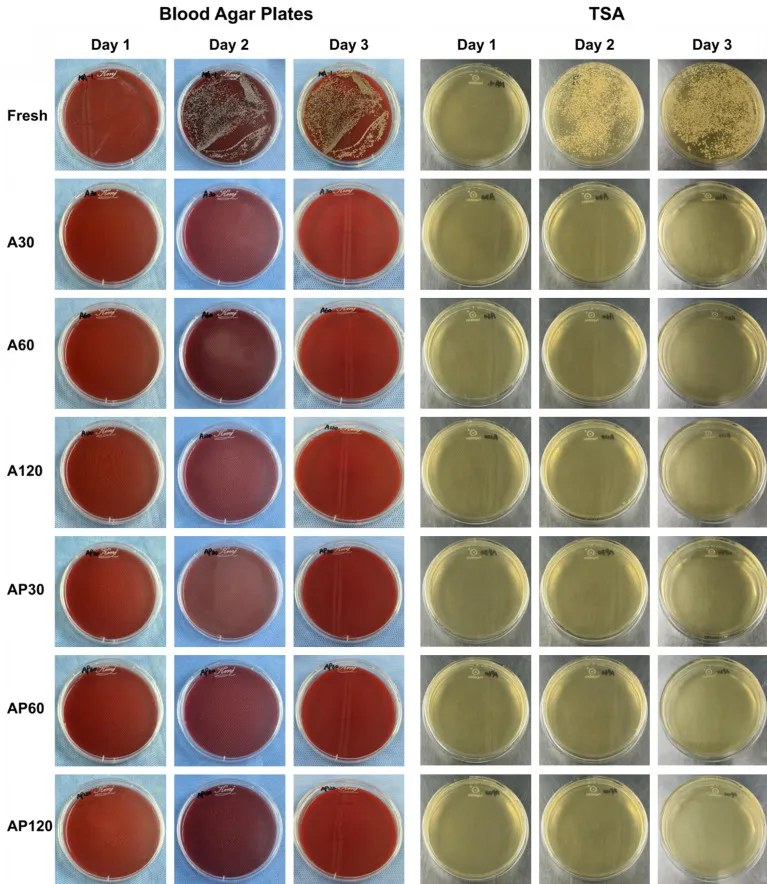

Hầm Biogas HDPE
Tác động của Dung dịch 75 Etanol trong Xử lý Vật liệu Địa Kỹ thuật Môi trường: Phân tích Toàn diện
Trong bối cảnh ngành Địa kỹ thuật Môi trường ngày càng phát triển, việc lựa chọn và xử lý vật liệu đóng vai trò then chốt để đảm bảo hiệu quả và độ bền của các công trình như bãi chôn lấp rác, hồ chứa nước thải, và các hệ thống xử lý chất thải nguy hại. Màng chống thấm HDPE và bạt nhựa HDPE là những vật liệu chủ lực được sử dụng rộng rãi nhờ khả năng chống thấm vượt trội và độ bền cao. Tuy nhiên, các quy trình xử lý, làm sạch hoặc khử trùng vật liệu, dụng cụ trong quá trình thi công và bảo trì cũng không kém phần quan trọng. Trong nhiều thập kỷ, dung dịch 75 Etanol đã khẳng định vị thế là một chất khử trùng hiệu quả và an toàn trong nhiều lĩnh vực, từ y tế đến phòng thí nghiệm. Nhưng tác động của nó lên tính chất cơ học, cấu trúc và tính tương thích của các vật liệu kỹ thuật, đặc biệt là trong môi trường khắc nghiệt, vẫn cần được làm rõ.
Bài viết này, dựa trên những phân tích khoa học chuyên sâu, sẽ đánh giá một cách toàn diện hiệu quả của dung dịch 75 etanol đối với các tính chất quan trọng của vật liệu, đồng thời rút ra những hàm ý thiết thực cho các ứng dụng trong lĩnh vực Địa kỹ thuật Môi trường, từ việc chuẩn bị mẫu kiểm tra Màng chống thấm HDPE, vệ sinh thiết bị máy hàn nhựa, cho đến các quy trình xử lý liên quan đến nước thải và chất thải nguy hại. Việc hiểu rõ tác động của 75 etanol sẽ giúp chúng ta tối ưu hóa các quy trình làm việc, đảm bảo chất lượng công trình và thúc đẩy năng lượng tái tạo và phát triển bền vững trong ngành.
I. Etanol 75%: Vai trò và Tầm quan trọng trong Quy trình Xử lý
Disinfection, hay khử trùng, là một bước thiết yếu trong việc chuẩn bị các vật liệu và dụng cụ để ngăn ngừa nhiễm trùng hoặc nhiễm bẩn, điều này không chỉ quan trọng trong y sinh mà còn trong nhiều quy trình công nghiệp và môi trường. Mặc dù 75 etanol không thể tiêu diệt bào tử vi khuẩn, nó vẫn được sử dụng rộng rãi như một chất khử trùng hiệu quả chống lại các tế bào vi khuẩn sinh dưỡng, nấm và hầu hết các loại virus. Cơ chế hoạt động của etanol là làm biến tính protein và phá vỡ hệ thống enzyme của vi sinh vật, từ đó vô hiệu hóa chúng.
Trong lĩnh vực Địa kỹ thuật Môi trường, việc sử dụng các dung môi làm sạch hoặc xử lý có thể cần thiết trong nhiều tình huống:
- Vệ sinh thiết bị và dụng cụ: Các máy hàn nhựa HDPE, dụng cụ cắt, hoặc các thiết bị đo lường thường xuyên tiếp xúc với môi trường đất, nước, chất thải, cần được làm sạch để đảm bảo hoạt động hiệu quả và ngăn ngừa lây nhiễm chéo.
- Chuẩn bị mẫu vật liệu: Khi lấy mẫu Màng chống thấm HDPE hoặc bạt nhựa HDPE để kiểm tra chất lượng, độ bền hoặc các tính chất khác trong phòng thí nghiệm, việc làm sạch bề mặt mẫu bằng 75 etanol có thể giúp loại bỏ tạp chất và vi sinh vật, đảm bảo kết quả chính xác hơn.
- Xử lý bề mặt tạm thời: Trong một số ứng dụng xử lý chất thải, đặc biệt là chất thải nguy hại, việc xử lý bề mặt các vật liệu hoặc khu vực tiếp xúc bằng 75 etanol có thể là một biện pháp hỗ trợ để kiểm soát vi sinh vật trước khi áp dụng các phương pháp xử lý chính.
Mặc dù việc sử dụng 75 etanol trong các quy trình địa kỹ thuật môi trường quy mô lớn có thể không phổ biến như trong y tế, nhưng việc hiểu rõ tác động của nó lên các vật liệu ở cấp độ vi mô vẫn mang lại giá trị to lớn. Điều này giúp chúng ta lựa chọn các quy trình xử lý phù hợp, đảm bảo an toàn cho vật liệu và môi trường.
II. Đánh giá Hiệu quả Khử trùng và Tương thích với Môi trường của 75 Etanol
Để đánh giá một chất xử lý như 75 etanol, không chỉ cần xem xét khả năng khử trùng mà còn phải xem xét tác động của nó lên vật liệu tiếp xúc và môi trường xung quanh. Nghiên cứu sâu rộng đã được thực hiện để làm rõ các khía cạnh này.
A. Hiệu quả Khử trùng của 75 Etanol
Kết quả nghiên cứu cho thấy 75 etanol có khả năng khử trùng hiệu quả. Khi các mẫu vật liệu được ngâm trong 75 etanol trong các khoảng thời gian khác nhau (30, 60 hoặc 120 phút), sau đó ủ trong môi trường nuôi cấy, không có khuẩn lạc vi khuẩn nào được quan sát thấy trong 72 giờ ủ. Ngược lại, nhóm mẫu không được xử lý (nhóm tươi) cho thấy sự phát triển khuẩn lạc rõ rệt ngay trong ngày đầu tiên.
Điều này chứng tỏ rằng, ngay cả việc ngâm trong 75 etanol chỉ trong 30 phút cũng đủ để đạt được hiệu quả khử trùng đáng kể trên các bề mặt tiếp xúc. Mặc dù nghiên cứu này tập trung vào vật liệu sinh học, nguyên lý khử trùng của 75 etanol vẫn áp dụng cho việc làm sạch các bề mặt dụng cụ, thiết bị trong Địa kỹ thuật Môi trường. Ví dụ, việc vệ sinh đầu hàn của máy hàn nhựa bằng 75 etanol có thể giúp loại bỏ các tạp chất vi sinh vật, đảm bảo mối hàn sạch và bền hơn. Đối với việc xử lý nước thải hoặc chất thải nguy hại, kiểm soát vi sinh vật trong các khu vực làm việc hoặc trên thiết bị cũng là một yếu tố quan trọng để duy trì vệ sinh và an toàn.
Figure 2
Figure 2
B. Tính Tương thích Sinh học và An toàn của Dung dịch 75 Etanol
Biocompatibility (tính tương thích sinh học) là một khái niệm quan trọng, mô tả mức độ vật liệu hoặc chất xử lý tương tác an toàn với các mô sống và chất lỏng cơ thể. Mặc dù các vật liệu địa kỹ thuật như Màng chống thấm HDPE không tương tác trực tiếp với cơ thể sống, nhưng tính an toàn của các chất xử lý được sử dụng với chúng, đặc biệt là trong môi trường nơi có sự sống (ví dụ: ao hồ, đất), vẫn là một mối quan tâm hàng đầu.
Các thử nghiệm đã được thực hiện để đánh giá độc tính tế bào (cytotoxicity) và tính tương thích máu (hemocompatibility) của vật liệu sau khi xử lý bằng 75 etanol.
- Thử nghiệm tan máu (Hemolysis test): Tất cả các nhóm mẫu được xử lý bằng 75 etanol đều cho thấy tỷ lệ tan máu dưới 5%, đáp ứng tiêu chuẩn ISO 10993-4:2002 về tính tương thích máu. Điều này cho thấy 75 etanol không gây tổn hại đáng kể đến hồng cầu.
- Phân tích độc tính tế bào (Cytotoxicity analysis): Sử dụng thử nghiệm CCK-8 với tế bào nguyên bào sợi L929, các nhóm được xử lý bằng 75 etanol (A30, A60, A120, AP30, AP60, AP120) cho thấy khả năng sống sót của tế bào vượt quá 70%. Mức này được coi là không gây độc tế bào theo tiêu chuẩn ISO. Ngược lại, nhóm tươi (không xử lý) có khả năng sống sót thấp hơn đáng kể (40.14% vào ngày 1 và 2.56% vào ngày 2).
 Figure 3
Figure 3
Những kết quả này chỉ ra rằng việc ngâm vật liệu trong 75 etanol trong thời gian ngắn (không quá 2 giờ) không gây ra độc tính đáng kể cho tế bào và có tính tương thích máu tốt. Trong ngữ cảnh Địa kỹ thuật Môi trường, điều này có nghĩa là 75 etanol là một chất xử lý tương đối an toàn khi tiếp xúc với môi trường sinh học hoặc khi được sử dụng bởi con người trong các quy trình làm việc. Nó ít có khả năng gây ra tác động tiêu cực đến môi trường nước hoặc đất nếu được sử dụng và thải bỏ đúng cách.
III. Tác động của 75 Etanol lên Cấu trúc và Tính chất Vật liệu
Hiểu được cách 75 etanol ảnh hưởng đến cấu trúc và tính chất cơ học của vật liệu là điều cần thiết để tối ưu hóa việc sử dụng nó trong các ứng dụng địa kỹ thuật, nơi vật liệu phải chịu đựng các điều kiện môi trường khắc nghiệt và tải trọng cơ học.
A. Hiệu quả Loại bỏ Tế bào và Mất nước
Dù 75 etanol là một chất khử trùng hiệu quả, nghiên cứu cho thấy nó không có khả năng loại bỏ tế bào một cách đáng kể. Các phân tích nhuộm H&E (Hematoxylin và Eosin) không cho thấy sự thay đổi rõ rệt nào về nhân tế bào giữa nhóm được ngâm etanol và nhóm tươi. Điều này có nghĩa là 75 etanol không phải là một giải pháp loại bỏ tế bào hoàn chỉnh cho các vật liệu sinh học phức tạp.
Tuy nhiên, một hiệu ứng đáng chú ý của việc ngâm trong 75 etanol là mất nước. Trọng lượng của vật liệu giảm đáng kể sau khi ngâm trong etanol, cho thấy quá trình khử nước diễn ra mạnh mẽ. Cụ thể, sau 30, 60 và 120 phút ngâm, trọng lượng vật liệu giảm đáng kể so với nhóm tươi. Điều thú vị là hiệu ứng mất nước này có thể đảo ngược. Sau khi rửa bằng dung dịch PBS (phosphate-buffered saline) trong 60 phút, trọng lượng vật liệu và hàm lượng DNA trở lại mức không khác biệt đáng kể so với nhóm tươi.
 Figure 4P<0.05, *P<0.01 so với nhóm tươi; #P<0.05, ##P<0.01 so với nhóm A120.
Figure 4P<0.05, *P<0.01 so với nhóm tươi; #P<0.05, ##P<0.01 so với nhóm A120.
Trong ngữ cảnh Địa kỹ thuật Môi trường, hiệu ứng mất nước này cần được lưu ý:
- Ảnh hưởng đến trọng lượng vật liệu: Đối với các vật liệu xốp hoặc hút nước, việc tiếp xúc với 75 etanol có thể làm thay đổi trọng lượng, điều này có thể quan trọng trong việc chuẩn bị mẫu hoặc cân đo chính xác.
- Khả năng phục hồi: Khả năng phục hồi sau mất nước cho thấy vật liệu không bị tổn hại vĩnh viễn, mà chỉ trải qua một sự thay đổi tạm thời. Điều này là một ưu điểm, bởi nó giảm thiểu rủi ro cho vật liệu nếu tiếp xúc với 75 etanol trong các quy trình làm sạch hoặc xử lý.
B. Tính chất Cơ học của Vật liệu sau xử lý bằng 75 Etanol
Tính chất cơ học như độ dày, độ cứng, độ bền kéo là những yếu tố cực kỳ quan trọng đối với các vật liệu địa kỹ thuật như Màng chống thấm HDPE và bạt nhựa HDPE, vì chúng quyết định khả năng chịu tải và tuổi thọ của công trình.
Nghiên cứu đã chỉ ra rằng việc ngâm trong 75 etanol có ảnh hưởng đáng kể đến các tính chất cơ học của vật liệu:
- Độ dày: Ngâm etanol làm giảm đáng kể độ dày của vật liệu, đặc biệt sau 60 và 120 phút. Tuy nhiên, sau khi rửa với PBS, độ dày đã phục hồi một phần và không có sự khác biệt đáng kể so với nhóm tươi. Điều này củng cố quan điểm về hiệu ứng mất nước tạm thời.
- Độ cứng (Modulus đàn hồi): Độ cứng của vật liệu tăng lên sau khi ngâm etanol, đặc biệt ở nhóm A60. Sau khi rửa với PBS, độ cứng giảm xuống và gần bằng với nhóm tươi, cho thấy hiệu ứng làm cứng tạm thời này có thể đảo ngược.
- Độ bền kéo cuối cùng (Ultimate tensile strength): Ngâm etanol cũng làm tăng độ bền kéo của vật liệu, với nhóm A60 và A120 cho thấy độ bền kéo cao hơn đáng kể so với nhóm tươi. Điều này cho thấy 75 etanol tạm thời tăng cường khả năng chống chịu lực kéo của vật liệu. Tương tự, hiệu ứng này cũng phục hồi sau khi rửa với PBS.
- Độ giãn dài tại điểm đứt (Elongation at break): Không có sự khác biệt đáng kể về độ giãn dài tại điểm đứt giữa các nhóm, cho thấy 75 etanol không ảnh hưởng đến khả năng co giãn của vật liệu.
 Figure 5P<0.05, *P<0.01 so với nhóm tươi; #P<0.05, ##P<0.01 so với nhóm A60.
Figure 5P<0.05, *P<0.01 so với nhóm tươi; #P<0.05, ##P<0.01 so với nhóm A60.
Các phát hiện này rất quan trọng đối với Địa kỹ thuật Môi trường. Mặc dù các vật liệu như Màng chống thấm HDPE và bạt nhựa HDPE có cấu trúc hóa học khác với vật liệu sinh học, nhưng việc hiểu rằng một dung môi như 75 etanol có thể gây ra những thay đổi tạm thời về độ dày, độ cứng và độ bền kéo, và rằng những thay đổi này có thể được phục hồi, cung cấp một cái nhìn sâu sắc. Nó gợi ý rằng nếu 75 etanol được sử dụng để làm sạch hoặc xử lý các vật liệu polyme, cần đảm bảo có bước rửa sạch để vật liệu trở về trạng thái ban đầu, tránh ảnh hưởng đến hiệu suất lâu dài. Điều này đặc biệt quan trọng cho các công trình đòi hỏi độ bền và tuổi thọ cao như bãi chôn lấp rác và hồ chứa chất thải.
C. Tính Toàn vẹn của Cấu trúc Ngoại bào (ECM) và Hàm ý cho Vật liệu Kỹ thuật
Cấu trúc ngoại bào (ECM) của vật liệu sinh học chủ yếu bao gồm collagen, elastin và glycosaminoglycans (GAGs), đóng vai trò quan trọng trong việc duy trì cấu trúc và chức năng. Đối với vật liệu kỹ thuật, “tính toàn vẹn cấu trúc” tương tự đề cập đến khả năng của vật liệu giữ được cấu trúc hóa học và vật lý của nó khi tiếp xúc với các yếu tố bên ngoài.
Các nghiên cứu nhuộm mô học đã chứng minh rằng cấu trúc của các thành phần ECM (sợi collagen, sợi elastin và GAGs) được bảo toàn tốt trên tất cả các nhóm mẫu sau khi xử lý bằng 75 etanol và rửa bằng PBS. Không có sự suy thoái hoặc biến đổi đáng kể nào của các thành phần ECM được quan sát thấy. Điều này cho thấy 75 etanol không gây tổn hại vĩnh viễn đến cấu trúc nền tảng của vật liệu.
 Figure 6
Figure 6
Mặc dù Màng chống thấm HDPE và bạt nhựa HDPE không có ECM, nhưng thông tin này vẫn có giá trị:
- Đảm bảo tính ổn định hóa học: Đối với các vật liệu polyme, việc tiếp xúc với các dung môi có thể gây ra hiện tượng trương nở, phân hủy hoặc thay đổi cấu trúc polyme. Nghiên cứu này cho thấy 75 etanol không phá vỡ cấu trúc cơ bản của vật liệu, điều này mang lại sự tự tin khi sử dụng nó để làm sạch hoặc xử lý các bề mặt polyme, miễn là tuân thủ thời gian tiếp xúc và có bước rửa sạch phù hợp.
- Ý nghĩa cho các vật liệu composite: Trong Địa kỹ thuật Môi trường, đôi khi các vật liệu composite hoặc vật liệu có nguồn gốc sinh học được sử dụng. Việc bảo tồn cấu trúc dưới tác động của 75 etanol là một điểm cộng lớn cho tiềm năng ứng dụng của nó.
IV. Thảo luận: Etanol 75% trong bối cảnh Địa kỹ thuật Môi trường và Máy hàn nhựa
Những phát hiện từ nghiên cứu này về tác động của dung dịch 75 etanol lên vật liệu mang lại nhiều thông tin quý giá, không chỉ cho lĩnh vực y sinh mà còn cho Địa kỹ thuật Môi trường và các ứng dụng liên quan đến Màng chống thấm HDPE, bạt nhựa HDPE, và máy hàn nhựa.
Đầu tiên, khả năng khử trùng hiệu quả của 75 etanol trong ít nhất 30 phút là một điểm mạnh. Trong môi trường làm việc của ngành Địa kỹ thuật Môi trường, nơi tiếp xúc với đất, nước, chất thải, và các yếu tố môi trường khác, việc duy trì vệ sinh cho thiết bị và dụng cụ là cần thiết. Máy hàn nhựa HDPE, các dụng cụ lấy mẫu, hoặc bề mặt làm việc trong các dự án xử lý chất thải có thể được làm sạch hiệu quả bằng 75 etanol để ngăn ngừa sự phát triển của vi sinh vật hoặc lây nhiễm chéo. Điều này không chỉ cải thiện an toàn lao động mà còn có thể kéo dài tuổi thọ của thiết bị bằng cách ngăn chặn sự ăn mòn sinh học do vi sinh vật gây ra.
Thứ hai, các thử nghiệm độc tính tế bào và tương thích máu cho thấy 75 etanol là một chất xử lý an toàn. Với tỷ lệ tan máu dưới 5% và khả năng sống sót của tế bào vượt quá 70%, nó đáp ứng các tiêu chuẩn ISO về an toàn sinh học. Điều này đặc biệt quan trọng khi xem xét các quy trình xử lý nước thải hoặc chất thải nguy hại, nơi các hóa chất được sử dụng cần phải có tác động môi trường tối thiểu và an toàn cho người lao động. Việc sử dụng 75 etanol như một chất làm sạch không độc hại cũng có thể là một lựa chọn thân thiện hơn với môi trường so với một số hóa chất mạnh khác.
Thứ ba, các tác động của 75 etanol lên cấu trúc và tính chất cơ học của vật liệu đã được làm rõ là mang tính chất tạm thời và có thể đảo ngược. Hiệu ứng mất nước làm giảm độ dày và tăng độ cứng, độ bền kéo của vật liệu, nhưng những thay đổi này hoàn toàn phục hồi sau khi rửa bằng PBS. Điều này có ý nghĩa quan trọng đối với Màng chống thấm HDPE và bạt nhựa HDPE. Nếu 75 etanol được sử dụng để làm sạch bề mặt hoặc chuẩn bị mẫu các vật liệu này, chúng ta có thể tin tưởng rằng tính toàn vẹn cấu trúc và các tính chất cơ học cốt lõi của vật liệu sẽ không bị ảnh hưởng vĩnh viễn, miễn là có bước rửa sạch đúng cách sau đó. Ví dụ, trong quá trình kiểm tra chất lượng vật liệu HDPE tại phòng thí nghiệm, việc sử dụng 75 etanol để làm sạch bề mặt mẫu trước khi thực hiện các phép đo độ bền kéo hoặc độ dày có thể được thực hiện mà không lo làm sai lệch kết quả cuối cùng.
Cuối cùng, việc bảo tồn các thành phần cấu trúc (như collagen, elastin, GAGs trong vật liệu sinh học) dưới tác động của 75 etanol cũng là một điểm đáng chú ý. Đối với vật liệu tổng hợp như HDPE, điều này ngụ ý rằng 75 etanol ít có khả năng gây ra sự phân hủy hóa học hoặc thay đổi cấu trúc polyme đáng kể trong thời gian ngắn. Sự ổn định này là một lợi thế khi sử dụng 75 etanol trong các quy trình làm việc đòi hỏi độ tin cậy cao của vật liệu.
Tóm lại, 75 etanol là một chất xử lý linh hoạt và đáng tin cậy. Dù nghiên cứu gốc tập trung vào ứng dụng y sinh, những nguyên lý và kết quả về hiệu quả khử trùng, tính an toàn sinh học, và tác động có thể đảo ngược lên tính chất vật liệu đều có thể được áp dụng rộng rãi trong các quy trình của Địa kỹ thuật Môi trường. Từ việc duy trì vệ sinh cho máy hàn nhựa đến việc chuẩn bị mẫu Màng chống thấm HDPE, hay thậm chí là các quy trình xử lý bề mặt trong môi trường chất thải, 75 etanol mang lại một giải pháp hiệu quả và an toàn.
V. Hạn chế và Hướng nghiên cứu Tiếp theo
Mặc dù nghiên cứu đã cung cấp những thông tin giá trị về tác động của dung dịch 75 etanol, vẫn còn một số hạn chế cần được khắc phục trong các nghiên cứu tương lai. Thứ nhất, nghiên cứu chưa sử dụng kính hiển vi điện tử để kiểm tra các thay đổi siêu cấu trúc của mô. Việc này có thể cung cấp cái nhìn sâu sắc hơn về những biến đổi tinh tế ở cấp độ nano do etanol gây ra, đặc biệt là trên các vật liệu polyme.
Thứ hai, tác động của 75 etanol lên các yếu tố tăng trưởng và cytokine trong ECM (đối với vật liệu sinh học) không được đánh giá. Mặc dù điều này ít liên quan trực tiếp đến Màng chống thấm HDPE, nhưng đối với các vật liệu composite hoặc vật liệu sinh học được sử dụng trong môi trường, việc hiểu tác động lên các thành phần hoạt tính sinh học có thể quan trọng.
Hướng nghiên cứu tiếp theo có thể tập trung vào:
- Đánh giá tác động của 75 etanol lên các loại vật liệu địa kỹ thuật cụ thể như HDPE, PVC, PE ở cấp độ vi mô bằng kính hiển vi điện tử.
- Nghiên cứu ảnh hưởng của 75 etanol lên các tính chất bề mặt của Màng chống thấm HDPE, ví dụ như năng lượng bề mặt, khả năng bám dính của các lớp phủ hoặc keo.
- Khảo sát tác động lâu dài của việc tiếp xúc lặp lại với 75 etanol lên các tính chất vật liệu và môi trường.
- So sánh 75 etanol với các chất làm sạch hoặc khử trùng khác thường được sử dụng trong ngành Địa kỹ thuật Môi trường để đưa ra khuyến nghị tối ưu nhất.
Kết luận
Nghiên cứu này đã khẳng định rằng việc ngâm vật liệu trong dung dịch 75 etanol ít nhất 30 phút có thể khử trùng hiệu quả mà không làm tổn hại đến tính tương thích sinh học, tính tương thích máu, tính toàn vẹn của cấu trúc và các tính chất cơ học quan trọng của vật liệu sau khi rửa sạch. Mặc dù 75 etanol có thể tạm thời làm tăng độ cứng và độ bền kéo của vật liệu do hiệu ứng mất nước, những thay đổi này hoàn toàn có thể đảo ngược sau khi rửa bằng PBS, giúp vật liệu trở lại các tính chất tương tự như trạng thái ban đầu.
Việc bảo tồn các thành phần cấu trúc chính và tuân thủ các tiêu chuẩn ISO về an toàn sinh học nhấn mạnh tính ứng dụng rộng rãi của 75 etanol trong việc xử lý vật liệu. Những phát hiện này không chỉ mở ra tiềm năng cho việc chuẩn bị vật liệu sinh học cho ứng dụng y sinh, mà còn hỗ trợ mạnh mẽ cho việc áp dụng 75 etanol như một quy trình làm sạch và xử lý hiệu quả, an toàn trong lĩnh vực Địa kỹ thuật Môi trường, đặc biệt là trong việc bảo trì máy hàn nhựa, xử lý các mẫu Màng chống thấm HDPE, và quản lý vệ sinh trong các dự án xử lý nước thải, chất thải nguy hại và bãi chôn lấp rác. Chúng tôi khuyến khích các chuyên gia và nhà thầu tìm hiểu thêm về các giải pháp địa kỹ thuật môi trường tiên tiến và công nghệ xử lý vật liệu để tối ưu hóa hiệu quả và độ bền cho các công trình.
Tài liệu tham khảo
- Qian K, Liu X, Jiang C. Disinfection methods for cardiovascular tissue engineering. J Biomed Mater Res B Appl Biomater. 2021;109(5):713-722.
- Rutala WA, Weber DJ. Guideline for disinfection and sterilization in healthcare facilities, 2008. Infect Control Hosp Epidemiol. 2008;29(2):107-117.
- Frantz C, Stewart KM, Weaver VM. The extracellular matrix at a glance. J Cell Sci. 2010;123(Pt 24):4195-4200.
- Lu P, Takai K, Weaver VM. The extracellular matrix: a dynamic niche in cancer progression. J Cell Biol. 2011;193(3):397-406.
- Humphrey JD, Dufresne ER, Schwartz MA. Mechanotransduction and extracellular matrix homeostasis. Nat Rev Mater. 2019;4(10):719-732.
- Xu Y, Li Z, Huang H, et al. Decellularized fish swim bladder as a novel scaffold for heart valve tissue engineering. Biomed Mater Eng. 2016;27(1):15-28.
- Zhao Y, Xu C, Gao Y, et al. An in situ endothelialization heart valve scaffold derived from fish swim bladder extracellular matrix. Biomater Res. 2022;26(1):10.
- Zhao Y, Zhang Z, Xu H, et al. Optimization of decellularization protocol for fish swim bladder and evaluation of its physicochemical properties. J Biomater Sci Polym Ed. 2021;32(1):1-16.
- Xu C, He X, Zhang T, et al. In vivo evaluation of a novel fish swim bladder-derived scaffold for heart valve repair. Int J Mol Sci. 2022;23(21):13444.
- Mirnajafizadeh S, Mohseni R, Shahrouz R, et al. Effects of different decellularization methods on the structural and mechanical properties of bovine pericardium. J Biomed Mater Res B Appl Biomater. 2021;109(1):14-23.
- Ramezani F, Alipour R, Dehghani H, et al. Decellularized porcine radial artery as a vascular scaffold for tissue engineering. J Biomed Mater Res B Appl Biomater. 2022;110(3):572-585.
- Xu Y, Wang Y, Xu C, et al. A novel method for decellularization of human umbilical veins using supercritical carbon dioxide. J Biomed Mater Res B Appl Biomater. 2018;106(6):2040-2049.
- Badylak SF, Freytes DO, Gilbert TW. Extracellular matrix as a biological scaffold material: structure and function. Acta Biomater. 2009;5(1):1-13.
- Schmidt CE, Baier RE. Biocompatibility of extracellular matrix-based biomaterials. Ann Biomed Eng. 2000;28(10):1084-1100.
- Yang M, Yu D, Cai Z, et al. Decellularized fish swim bladder as a scaffold for bone tissue engineering. J Mater Sci Mater Med. 2018;29(3):30.
- Freytes DO, Badylak SF, Webster TJ. The use of decellularized porcine urinary bladder matrix for soft tissue repair. Biomaterials. 2009;30(33):6534-6541.
- Kropp BP, Rippy MK, Lundak AP, et al. Regenerative bladder augmentation using a bladder acellular matrix in a canine model. J Urol. 1996;155(6):2098-2104.
- Poornejad N, Razavi M, Tayebi L, et al. Decellularization of whole porcine kidney: effects on morphology, biochemistry, and biocompatibility. J Biomed Mater Res A. 2016;104(7):1676-1685.
- Hussein MA, El-Fadly E, El-Sayed EM. Decellularized porcine liver as a scaffold for liver tissue engineering. J Biomed Mater Res B Appl Biomater. 2018;106(2):494-503.
- Pati F, Jang J, Kim JW, et al. Design and fabrication of 3D bone scaffolds by decellularization and 3D bioprinting. Mater Sci Eng C Mater Biol Appl. 2015;48:29-35.
- Gilbert TW, Stewart-Akers AM, Badylak SF. Degenerative changes in the extracellular matrix of a long-term xenogeneic bioscaffold. J Biomed Mater Res A. 2007;81(4):783-792.
- Courtman DW, Pereira CA, Sinanan MN, et al. The effect of chemical processing on the mechanical properties and biological activity of bovine pericardium. J Biomed Mater Res. 1999;47(4):539-547.
- Hussein MA, El-Fadly E, El-Sayed EM. The effect of different decellularization methods on the structural integrity and mechanical properties of porcine liver. J Biomed Mater Res B Appl Biomater. 2017;105(7):2020-2030.
- Crapo PM, Medberry CJ, Reing JE, et al. Disinfection and sterilization of biologic scaffolds. Tissue Eng Part B Rev. 22(1):49-65.
- Lumpkins KM, Smith C, Loya E, et al. Decellularized porcine intervertebral disc as a scaffold for disc tissue engineering. J Orthop Res. 2013;31(2):331-339.
- Guimaraes S, Simões D, Pereira R, et al. The effects of different decellularization methods on the structural and mechanical properties of porcine trachea. J Biomed Mater Res B Appl Biomater. 2021;109(5):789-801.
- Tarnowski M, Dziubinska H, Gaczkowska A, et al. Hydration and mechanical properties of collagen fibers after ethanol treatment. J Biomech Eng. 2014;136(5):051006.
- Sergeevichev D, Gureev S, Vlasov V, et al. Effects of decellularization methods on the mechanical properties of porcine carotid arteries. J Biomed Mater Res B Appl Biomater. 2018;106(7):2409-2419.























































































